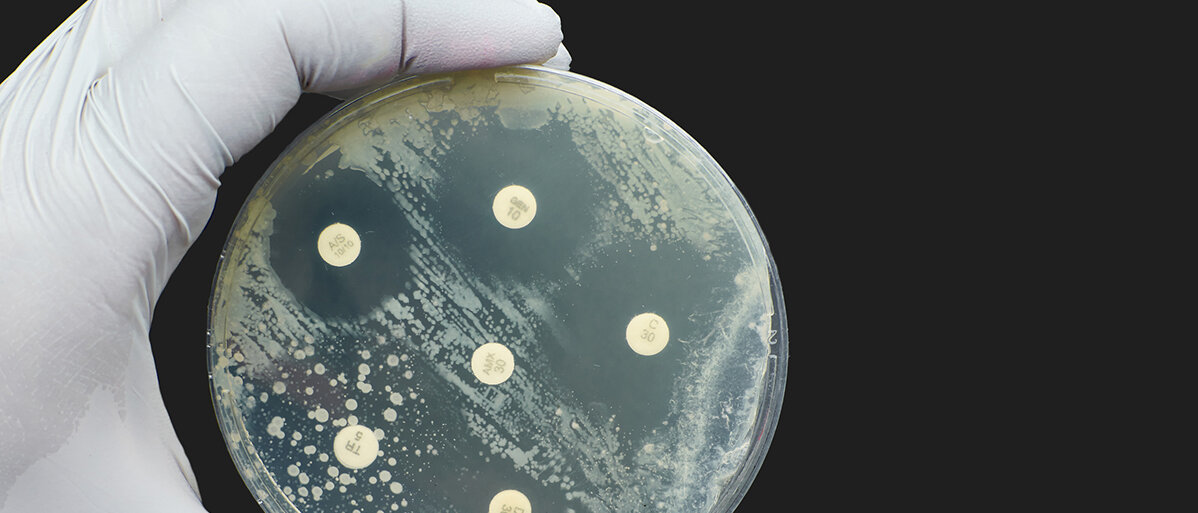

Resistenzen
KRANKENHAUSKEIM STÖSST ANTIBIOTIKAENTWICKLUNG AN
Seite 1/1 2 Minuten
Schon Alexander Fleming orientierte sich (allerdings ohne es zu wissen) bei der Entdeckung des ersten Antibiotikums an der Natur: Wo Penicillium notatum in der Petrischale wucherte, wuchs um ihn herum kein Bakterium mehr.
Als Gegenwehr haben Bakterien und Pilze viele Möglichkeiten entwickelt, andere Mikroorganismen abzutöten. Meistens greifen sie dabei lebenswichtige Proteine der Mikroorganismen an oder zielen direkt aufs Erbgut. Das neu entdeckte Toxin von Pseudomonas aeruginosa richtet sich allerdings gegen die RNA, die die Umsetzung der Erbinformation zu Proteinen vermittelt. Das bedeutet: ein ganz neuer Ansatz.
Neuer Ansatz: RNA attackieren
Bei Bakterien ist die Erbinformation – wie auch bei Menschen, Pflanzen, Tieren und Pilzen – in der DNA gespeichert. RNA nutzen Bakterien dennoch in ebenso vielfältiger Funktion wie wir auch:
- messengerRNA (mRNA) fungiert als Transporter der DNA-Kopie eines bestimmten Genabschnittes (wie ein Bauplan) während der Zellteilung,
- transferRNA (tRNA) schafft einzelne Aminosäuren heran, damit sie zu neuen Proteinen aufgebaut werden können,
- ribosmale RNA (rRNA) stellt den Hauptbestandteil von Ribosomen, die im Zellteilungsprozess als Treffpunkt für mRNA und tRNA fungieren und
- Ribozyme heißen weitere Helferlein auf dem Weg zum korrekten Molekül; und sie fungieren gleichzeitig auch noch als Müllabfuhr gebrauchter RNA-Schnipsel.
Man sieht: Ohne funktionsfähige RNA-Moleküle kann eine Zelle nicht überleben. Und das ist der entscheidende Punkt.
P. aeruginosa ist ein Meister der verdeckten Abwehr
In diese Lücke stößt das Bakterium Pseudomonas aeruginosa, das von Natur aus gegen zahlreiche Antibiotika resistent ist. Ein Team um Nathan Bullen von der McMaster University in Hamilton, Kanada, hat nun herausgefunden, dass P. aeruginosa selbst ein Toxin absondert, das als Antibiotikum wirkt und andere Bakterienarten abtötet. Wie es das macht? Indem es auf essenzielle RNA-Moleküle abzielt und sie dadurch funktionsunfähig macht.
Eine bestimmte ART-Transferase, die wie ein Bus den einzufügenden RNA-Schnipsel vom Donator zum Akzeptor bringt, wird von dem Bakterium selbst produziert. Diese bewirkt bei der ursprünglichen Zelle ordnungsgemäße Bauanleitungen, doch hier hat sie nur den einen Zweck: die Bauanleitungen zu stören. Das hat P. aeruginosa zwar nicht neu erfunden – Cholera, Diphterie und Keuchhusten funktionieren auch so – doch es gibt einen entscheidenden Unterschied: Alle bisher bekannten ART-Toxine zielen auf Proteine, nicht auf RNA.
Mehr aus der Antibiotikaforschung
Arzneimittelforscher schauen sich den Trick ab
Dieses ungemein erfolgreiche Konzept weckte das Interesse der Wissenschaftler. Unter anderem stört das Gift die Aktivität der tRNAs, die eigentlich die Bausteine für die Proteine an die richtige Stelle bringen sollen. Außerdem behindert es noch ein Ribozym, das für den Abbau von RNA-Molekülen zuständig ist. „Infolge der Hemmung der Proteinbiosynthese und durch die Störung des Abbaus der tRNAs wird der Zelltod ausgelöst“, so die Forschenden.
„Insgesamt zeigen unsere Daten einen bisher unbeschriebenen Mechanismus des bakteriellen Antagonismus und enthüllen eine zuvor unbekannte Aktivität von ART-Enzymen.“
Diese Entdeckung kann dazu beitragen, eine neue Klasse von Antibiotika zu entwickeln, meinen die Forschenden. Diese nutzen dann die gleiche Schwachstelle wie das Toxin von P. aeruginosa. Und das wiederum könnte helfen, Behandlungsmöglichkeiten gegen Erreger zu finden, die gegen die meisten bisher existierenden Antibiotika resistent sind.
Quelle: wissenschaft.de